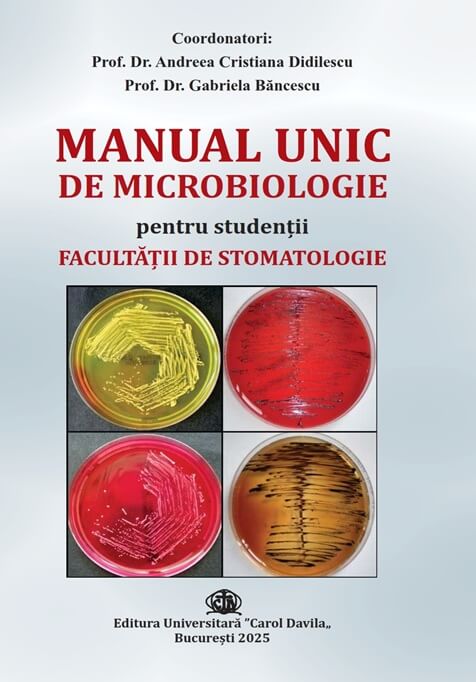

Program Editura Universitară "Carol Davila"
- Luni-Vineri 8:00-16:00
Anunț
Vă rugăm ca toate plățile în contul editurii prin virament bancar să nu se mai realizeze prin REVOLUT. Vă mulțumim!
Manuale de Rezidențiat
Editura Universitară "Carol Davila"
Editura Universitară „Carol Davila” a fost înființată la data de 1.08.1995 prin Ordinul Ministrului Învățământului 4577/1995, comunicat de Ministerul Învățământului – Direcția de Învățământ Superior și Cercetare Științifică Universitară, prin adresa
nr. 35539/27.07.1995.
Sediul Editurii Universitare „Carol Davila” este în București, Bulevardul Eroii Sanitari, Nr. 8, Sector 5.
E-mail: editura@umfcd.ro.
Mai mult3850
Peste 3850 titluri de carte publicate
Materiale pentru admitere
Vrei să fii student la UMFCD?
Universitatea de Medicină și Farmacie ”Carol Davila” Bucuresti.
Află mai multe aici.